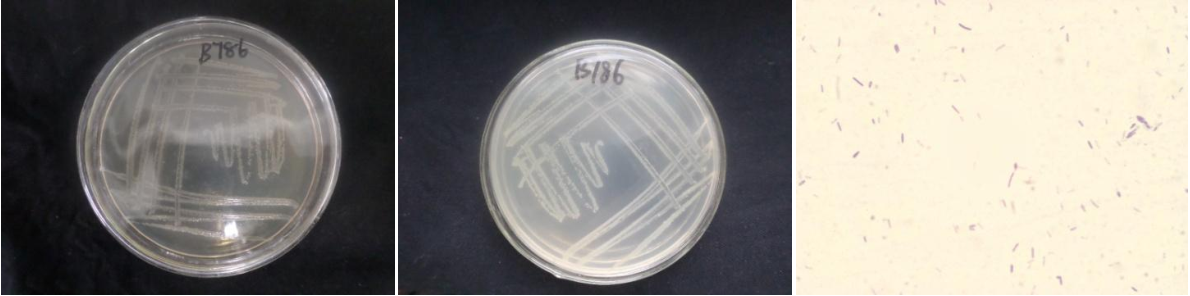

Loading...
| StrainNO | B786 |
| Classification | Brevibacillus |
| 16s rDNA sequence | GCAAGTCGAGCGAGTCTCTTCGGAGGCTAGCGGCGGACGGGTGAGTAACACGTAGGCAACCTGCCTCTCAGACTGGGATAACATAG GGAAACTTATGCTAATACCGGATAGGTTTTCGGATCGCATGATTCGAAAAGAAAAGGCGGCTTCGGCTGTCACTGGGAGATGGGCC TGCGGCGCATTAGCTAGTTGGTGGGGTAACGGCCTACCAAGGCGACGATGCGTAGCCGACCTGAGAGGGTGACCGGCCACACTGGG ACTGAGACACGGCCCAGACTCCTACGGGAGGCAGCAGTAGGGAATTTTCCACAATGGACGAAAGTCTGATGGAGCAACGCCGCGTG AACGATGAAGGTCTTCGGATTGTAAAGTTCTGTTGTTAGGGACGAATAAGTACCGTTCGAATAGGGCGGTACCTTGACGGTACCTG ACGAGAAAGCCACGGCTAACTACGTGCCAGCAGCCGCGGTAATACGTAGGTGGCAAGCGTTGTCCGGATTTATTGGGCGTAAAGCG CGCGCAGGCGGCTATGTAAGTCTGGTGTTAAAGCCCGGGGCTCAACCCCGGTTCGCATCGGAAACTGTGTAGCTTGAGTGCAGAAG AGGAAAGCGGTATTCCACGTGTAGCGGTGAAATGCGTAGAGATGTGGAGGAACACCAGTGGCGAAGGCGGCTTTCTGGTCTGTAAC TGACGCTGAGGCGCGAAAGCGTGGGGAGCAAACAGGATTAGATACCCTGGTAGTCCACGCCGTAAACGATGAGTGCTAGGTGTTGG GGGTTTCAATACCCTCAGTGCCGCAGCTAACGCAATAAGCACTCCGCCTGGGGAGTACGCTCGCAAGAGTGAAACTCAAAGGAATT GACGGGGGCCCGCACAAGCGGTGGAGCATGTGGTTTAATTCGAAGCAACGCGAAGAACCTTACCAGGTCTTGACATCCCGCTGACC GCTCTGGAGACAGAGCTTCCCTTCGGGGCAGCGGTGACAGGTGGTGCATGGTTGTCGTCAGCTCGTGTCGTGAGATGTTGGGTTAA GTCCCGCAACGAGCGCAACCCTTATCTTTAGTTGCCAGCATTCAGTTGGGCACTCTAGAGAGACTGCCGTCGACAAGACGGAGGAA GGCGGGGATGACGTCAAATCATCATGCCCCTTATGACCTGGGCTACACACGTGCTACAATGGTTGGTACAACGGGATGCTACCTCG CGAGAGGACGCCAATCTCTTAAAACCAATCTCAGTTCGGATTGTAGGCTGCAACTCGCCTACATGAAGTCGGAATCGCTAGTAATC GCGGATCAGCATGCCGCGGTGAATACGTTCCCGGGCCTTGTACACACCGCCCGTCACACCACGGGAGTTTGCAACACCCGAAGTCG GTGAGGTAACCGCAAGGAGCCAGCCG |
| Strain Morphology Photos | |
| Morphological Description | Colony round;clam white;Finely toothed and convex edge、flat in the middle;multifold;slippy;sticky;Waxed;Rod;having spore;Mesophilic budding spore |